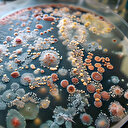
Bilim adamlarının 10 yılda çözemediğini yapay zeka 48 saatte çözdü: İşte tıp dünyasında çığır açacak o araştırma

Foto: Arşiv
2025 Şubat ayında Türkiye'nin savunma ve havacılık sektörü ihracatı 434 milyon dolara ulaştı.
Cumhurbaşkanlığı Savunma Sanayii Başkanı
Haluk Görgün
, X hesabından yaptığı açıklamada, 2025 yılı şubat ayında savunma ve havacılık ihracatının, geçen yılın aynı dönemine göre yüzde 44’lük artış göstererek 300 milyon dolardan 434 milyon dolara yükselerek rekor kırdığını belirtti.
"Savunma sanayimiz yükselmeye devam edecek"
"Savunma sanayimiz yükselmeye devam edecek"
Yılın ilk 2 ayındaki toplam ihracatın ise yüzde 29,6 artışla 816 milyon dolara ulaştığına dikkati çeken Görgün, şu ifadeleri kullandı:
"Türkiye’nin savunma sanayisi, küresel pazarda daha güçlü bir konuma yükseliyor. Hedefimiz: katma değerli ürünlerde sürdürülebilir artış. Yüksek teknolojiye dayalı, katma değeri yüksek ürünlerimizin ihracatında kalıcı bir artış trendi yakalamayı hedefliyoruz. Başkanlığımızın yürüttüğü kesintisiz uluslararası işbirliği faaliyetleri ile şirketlerimizin maliyet etkin-yüksek teknoloji çözümleri sayesinde sektörümüz belli bir bölgeye değil, dünyanın dört bir yanına ihracat yapabilir hale gelmiştir. Önümüzdeki dönemde, hem büyük ölçekli şirketlerimizi hem de KOBİ’lerimizi destekleyen, ihracat yapan firma sayımızı artıran ve ihracatı tüm sektör için sürdürülebilir bir güç haline getiren uluslararası faaliyetlerimizi kararlılıkla sürdüreceğiz. Bu büyük başarıda emeği geçen başkanlığımız personelini, şirketlerimizi, KOBİ'lerimizi, mühendislerimizi ve sektör paydaşlarımızı tebrik ediyorum. Savunma sanayimiz yükselmeye devam edecek."
#Haluk Görgün
#ihracat
#teknoloji